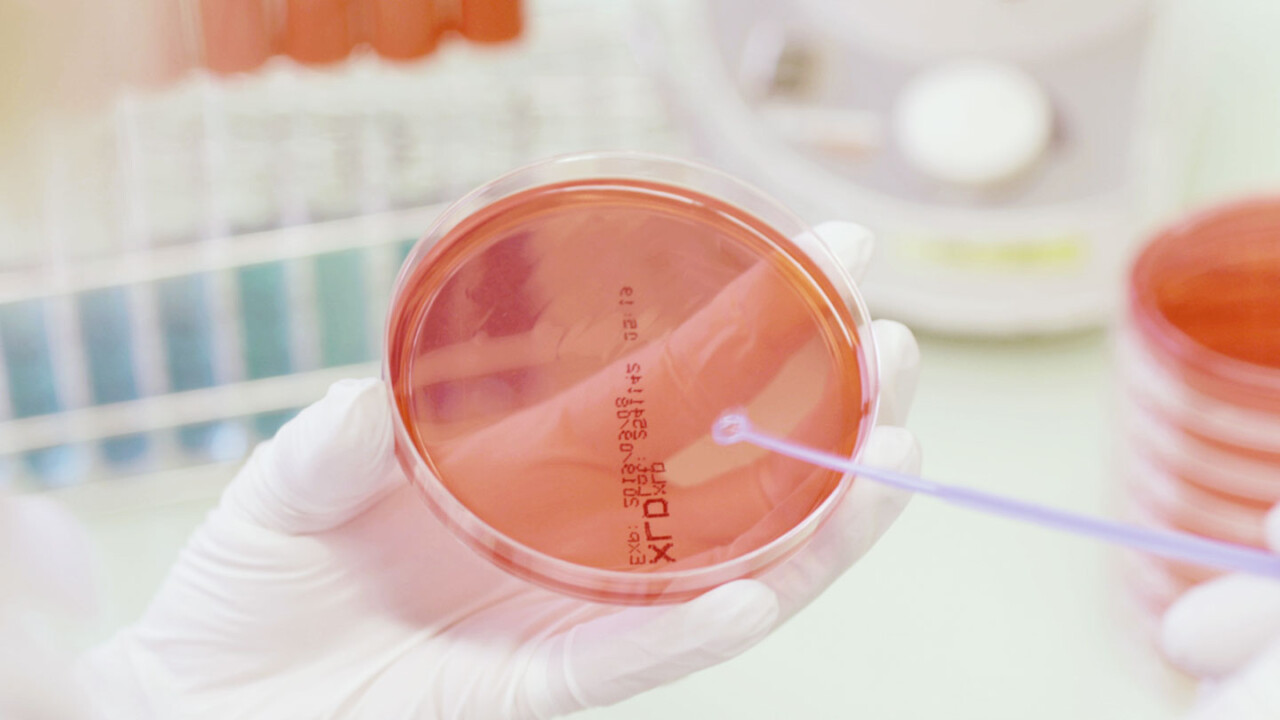
Nahaufnahme einer gloved Hand im Labor, die eine Petrischale mit rötlichem Nährmedium hält. Mit einem sterilen Tupfer wird eine Probe aufgetragen – Symbolbild für chemisch-analytische Untersuchungen, Qualitätskontrolle sowie Sicherheit und Authentizität von Lebensmitteln.

Biotechnologie
NGS-basierte Analytik
Biotechnologie, Lebensmittelsicherheit und Biomassefermentation
Die Forschungsplattform Biotechnologie nutzt biologische Ressourcen zur Schaffung sicherer Lebensmittel
Dabei liegt unser Fokus auf der Gewährleistung der Lebensmittelsicherheit und der effizienten Biomassefermentation. Ein zentrales Ziel unserer Arbeit ist die Maximierung der Lebensmittelsicherheit entlang der gesamten Wertschöpfungskette. Wir setzen auf die biologische Bekämpfung von unerwünschten Mikroorganismen, auch Biocontrol genannt, indem wir gezielt lebende Starterkulturen, Bakteriophagen und natürliche antimikrobielle Substanzen einsetzen. Diese innovativen Ansätze erhöhen die Produktsicherheit auf natürliche und effektive Weise.
Mithilfe unserer hochmodernen Next-Generation-Sequencing-Plattform (NGS) analysieren wir die komplexen Interaktionen zwischen diesen biologischen Mitteln und der natürlichen Mikrobiota fermentierter Lebensmittel. Dieses tiefgehende Verständnis ermöglicht es uns, Fermentationsprozesse zu optimieren und die sensorischen Eigenschaften wie Geschmack und Textur zu verbessern. So steigern wir nicht nur die Attraktivität der Produkte, sondern gewährleisten auch ihre Unbedenklichkeit für den Konsumenten.

Biotechnologie nutzt Mikroorganismen gezielt für sichere, nachhaltige und attraktive Lebensmittel und prägt die Ernährung von morgen.
Mehr über unsere Forschungsabteilung erfahren?

Biomassefermentation als Schlüssel zu alternativen Proteinen und Fleischersatzprodukten
Ein weiterer Schwerpunkt der Biotechnologie ist die Biomassefermentation. Wir erforschen und entwickeln Mikroorganismen und Verfahren zur Herstellung von essbarem Single-Cell-Protein (SCP) aus Pilzen (Mykoprotein) und Single-Cell-Oil (SCO). Hierbei optimieren wir den Prozess im Sinne der Kreislaufwirtschaft für maximale Nachhaltigkeit.
Unsere Forschung konzentriert sich auf die Nutzung von Nebenströmen aus der Landwirtschaft und Lebensmittelverarbeitung als Ausgangsstoffe. Diese Nebenströme werden gezielt als Ausgangsstoffe für die Fermentierung genutzt. Diese alternativen Proteine und Fette, gewonnen aus der Aufwertung von Nebenprodukten, sind nährstoffreich und bilden die Basis für gesunde, proteinreiche Lebensmittel.
Unsere Forschungsmethoden
- Maximierung der Lebensmittelsicherheit entlang der gesamten Wertschöpfungskette
- Biologische Bekämpfung unerwünschter Mikroorganismen (Biocontrol)
- Einsatz lebender Starterkulturen zur Erhöhung der Produktsicherheit
- Nutzung natürlicher antimikrobieller Substanzen zur Produktsicherheit
- Natürliche und gleichzeitig effektive Steigerung der Lebensmittelsicherheit
- Einsatz einer hochmodernen Next-Generation-Sequencing-Plattform (NGS)
- Analyse der Interaktionen zwischen biologischen Wirkstoffen und natürlicher Mikrobiota fermentierter Lebensmittel
- Optimierung von Fermentationsprozessen
- Verbesserung sensorischer Eigenschaften wie Geschmack und Textur
- Sicherstellung der Unbedenklichkeit fermentierter Produkte für Konsument:innen
- Entwicklung von Mikroorganismen und Verfahren zur Herstellung mikrobieller Biomasse für Lebensmittelanwendungen
- Nutzung von Nebenströmen aus Landwirtschaft und Lebensmittelverarbeitung als Fermentationssubstrate
- Aufwertung von Nebenprodukten zu nährstoffreichen, proteinreichen Lebensmittelzutaten
- Beitrag zu ressourcenschonender, klimafreundlicher Lebensmittelproduktion
- Herstellung von Single-Cell-Protein (SCP) aus Pilzen (Mykoprotein)
- Produktion von Single-Cell-Oil (SCO) als alternative Fettquelle
- Entwicklung innovativer Fleischersatz- und Proteinprodukte auf Basis mikrobieller Biomasse
- Unterstützung einer nachhaltigen, zukunftsfähigen Ernährung auf Basis alternativer Proteine und Fette
Aktuelle Forschungsprojekte
| Projektbezeichnung | Projekttitel | Projektende |
|---|---|---|
| Lytische Enzyme | Nutzbarmachung der Bildung von und Resistenz gegen lytische Enzyme von Laktobazillen in der Rohwurstreifung | 01.11.2023 |
| Fermentate mit anti-gramnegativer Aktivität | Konsekutive fungale und bakterielle Biokonversion zur Herstellung von Fermentaten mit anti-gramnegativer Aktivität | 31.01.2024 |
| Salmonellen-Inaktivierung in Schokolade | Inaktivierung getrockneter, hitzetoleranter Salmonellen in der Schokoladenproduktion | 01.02.2025 |
| Sporenbelastung von Fleischersatzprodukten | Vorkommen und Verhalten sporenbildender Bakterien in Fleischersatzprodukten | 01.01.2026 |
| Listerienreduktion mit Hochdruck und Phagen | Reduktion von Listeria monocytogenes in Fleischerzeugnissen durch Kombination von Hochdruck und Bakteriophagen | 01.04.2025 |




